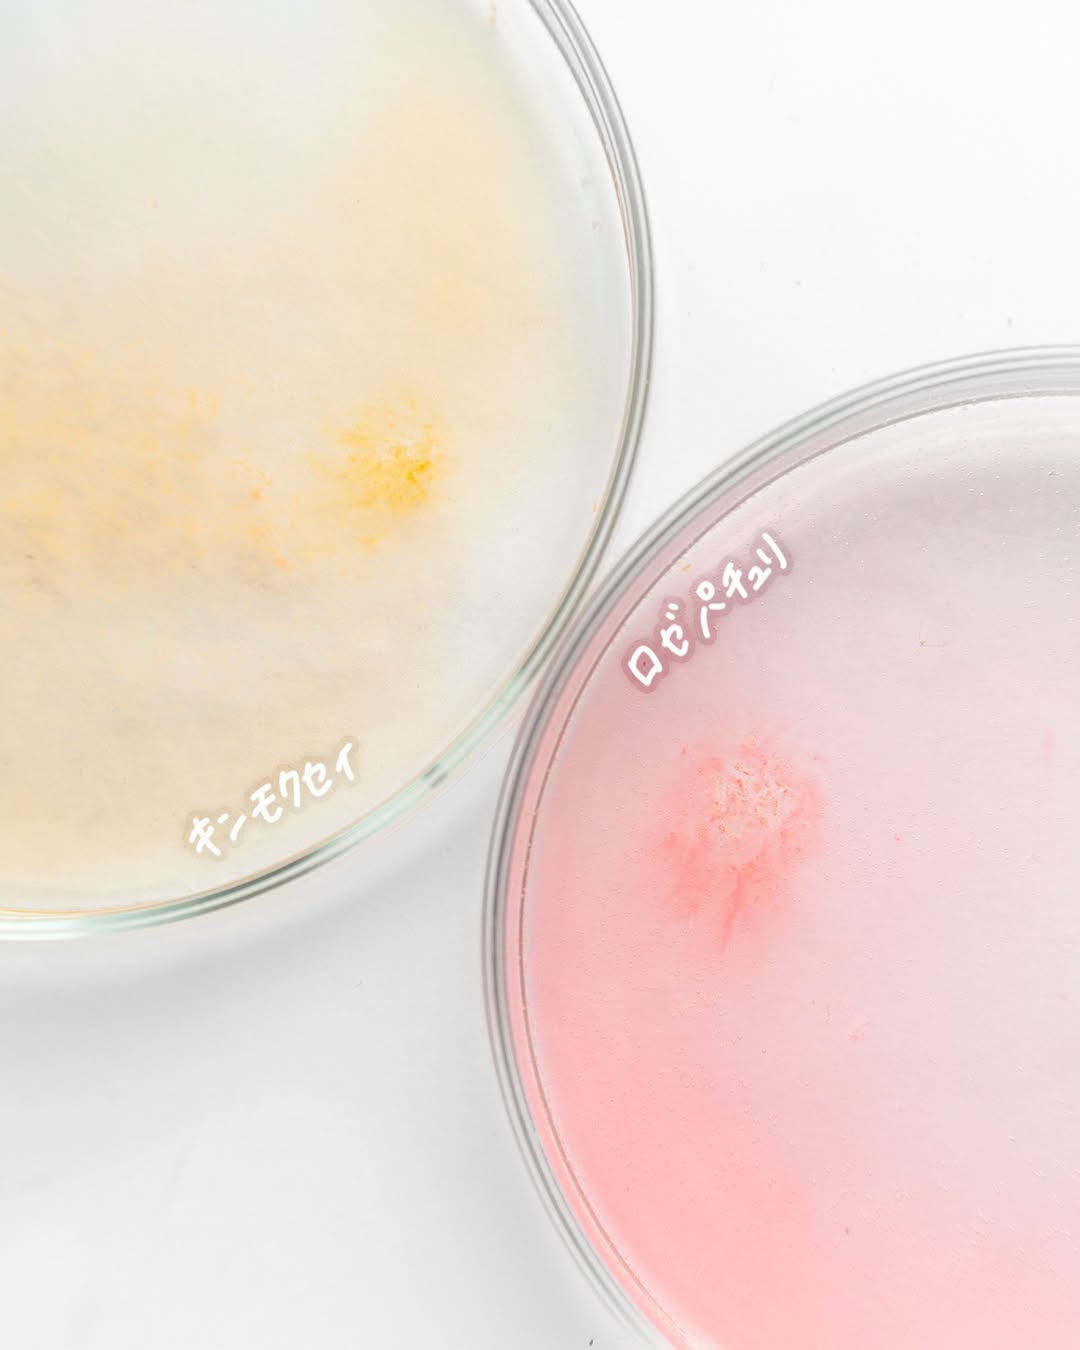

◀
▶
汗かきエステ気分を楽しめる
スペシャリテ エプソムソルト シリーズ🛁
1回分がたっぷり100g!
エプソムソルト(硫酸マグネシウム)で
ゆっくり浸かるの時間がほんと至福
ボリュームも満足だし、
香りがたまらない🤍
疲れたときにホッとできる香り
キンモクセイは甘すぎず軽やかで爽やか
ロゼパチュリはハーブ×フローラルのような
柔らかく上品な香り🌿🌹
香りもしっかりめで長く続くから
つい億劫になりがちな入浴も気分が上がる♨️
──────────────────
📍┆汗かきエステ気分 スペシャリテ エプソムソルト
📄┆キンモクセイ/ロゼパチュリ
🔭┆@maxcosme1905
🔎┆#PR #株式会社マックス #汗かきエステ気分 #汗かきエステ #入浴剤 #バスソルト #バスタイム #お風呂グッズ #エプソムソルト #ロゼパチュリ #キンモクセイ #マックス石鹸 #マックスコスメ #monipla #soapmax_fan
Instagramの投稿へ
投稿日時:2025/11/02
提供:株式会社マックス


![]()
![]()
![]()
![]()
![]()